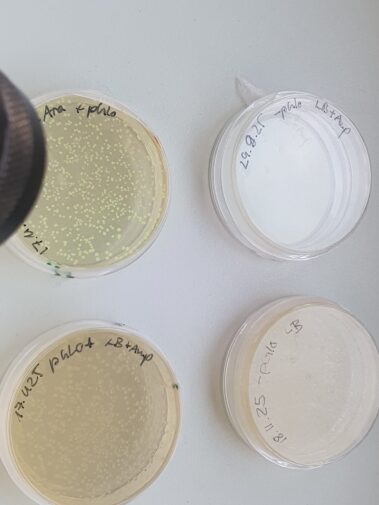

Kompetente Zellen, Antibiotikaresistenzen und leuchtende Bakterien: Der Biologiekurs der Jahrgangsstufe 13 hat einen molekularbiologischen Laborkurs im Gläsernen Labor in Berlin-Buch zum Thema Klonierung absolviert und sich mit gentechnischen Methoden und ihrer praktischen Umsetzung vertraut gemacht.
Zunächst wurden Restriktionsenzyme genutzt, um ein Plasmid aufzuschneiden und seine Größe und Zusammensetzung durch Auftrennen der entstandenen Fragmente mittels Agarose-Gelelektrophorese zu prüfen. Danach erfolgte eine Transformation mit dem ungeschnittenen Rest des Plasmids in Bakterien. Bei erfolgreicher Übertragung des genetischen Materials waren die Bakterien anschließend in der Lage, auf Nährböden mit dem Antibiotikum Ampicillin zu wachsen und durch zusätzliche Zugabe des Zuckers Arabinose unter UV-Licht zu leuchten.
Vielen Dank an die Mitarbeiter des Gläsernen Labors für die engagierte Betreuung des Praktikums!